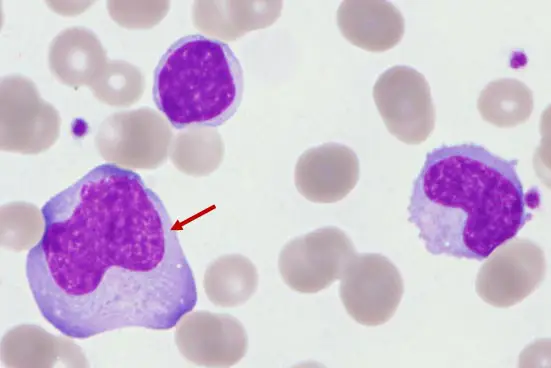
圖片描述

114年:(醫檢)血液(1)
圖中箭號所指細胞為何?
AMetamyelocyte
BBlast
CMonocyte
DReactive lymphocyte
詳細解析
本題觀念:
聚焦於外周血塗片中各類白血球成熟階段或反應性細胞的形態辨識,特別是反應性(atypical)淋巴球與骨髓左移細胞(如metamyelocyte)及單核球、blast 之鑑別。
影像分析:
從顯微圖可見箭頭所指細胞:
- 細胞體積較周圍紅血球顯著增大,直徑估約15–20μm。
- 豐富且深藍(basophilic)的胞質,且胞質與相鄰紅血球緊密貼合出現「齒狀」或「裙襬狀」的切跡(scalloping)現象。
- 核形不規則、皺摺或凹陷,染色質較為緻密呈粗塊狀,無明顯嗜鹼性顆粒。
- 未見明顯顆粒或多核葉裂。整體呈異質(pleomorphic)群體。
這些特徵符合外周血中反應性淋巴球(reactive lymphocyte)的典型形態。
選項分析
- 選項A Metamyelocyte
Metamyelocyte 為顆粒性系列細胞成熟階段,核已輕度凹陷(凹陷程度<半個核直徑),胞質含大量特異性(specific)顆粒及少數原生(azurophilic)顆粒,呈微粒狀外觀,且通常不出現在正常外周血中,或僅在骨髓左移過度時才見(en.wikipedia.org)。箭頭細胞胞質平滑無顆粒,且深藍色而
...(解析預覽)...

升級 VIP 解鎖圖文解析